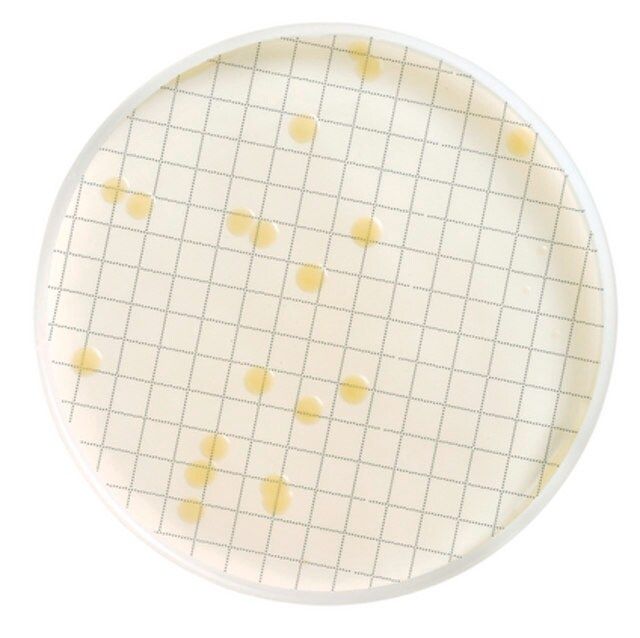

ن؛§ه“پهگچ称9ü/div>
2,2-DIMETHYL-4-PENTEN-1-OL
ن؛§ه“پن»‹ç»چï¼™ü/div>
ن؛§ه“پ说وکژ
ه…¶ن»–说وکژ
Please note that sigma-aldrich provides this product to early discovery researchers as part of a collection of rare and unique chemicals. sigma-aldrich does not collect analytical data for this product. Buyer assumes responsibility to confirm product identity and/or purity. All sales are final.
NOTWITHSTANDING ANY CONTRARY PROVISION CONTAINED IN SIGMA-ALDRICH'S STANDARD TERMS AND CONDITIONS OF SALE OR AN AGREEMENT BETWEEN SIGMA-ALDRICH AND BUYER, SIGMA-ALDRICH SELLS THIS PRODUCT AS-IS AND MAKES NO REPRESENTATION OR WARRANTY WHATSOEVER WITH RESPECT TO THIS PRODUCT, INCLUDING ANY (A) WARRANTY OF MERCHANTABILITY; (B) WARRANTY OF FITNESS FOR A PARTICULAR PURPOSE; OR (C) WARRANTY AGAINST INFRINGEMENT OF INTELLECTUAL PROPERTY RIGHTS OF A THIRD PARTY; WHETHER ARISING BY LAW, COURSE OF DEALING, COURSE OF PERFORMANCE, USAGE OF TRADE OR OTHERWISE.
هں؛وœ¬ن؟،وپ¯
| ç؛؟و€§هˆ†هگه¼ڈ |
C7H14O |
| هˆ†هگé‡ژü/td> |
114.189 |
| MDLç¼–هڈ· |
MFCD11055010 |
 m.cnreagent.com
m.cnreagent.com